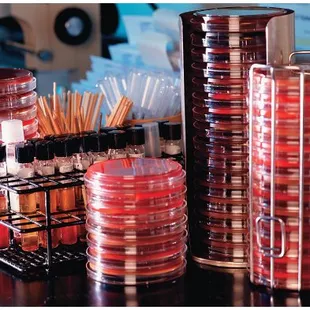

Taking a closer look on the heart

Dissecting a pig heart

Dissected pig kidney

Pig Heart and valves

Pig heart

Dissected pig heart

Samantha G.
Apr 12, 2022
CIMS is a great place to learn. Most of the staff are not only amazing, professional and welcoming but friendly and helpful. Sherrie was so helpful with registering and helping with any and all problems with ADB. Mr. Jackson is a man of few words but always welcoming and helpful. Ms. B is an amazing instructor, she's tough but exactly what is needed to prepare you for the medical field. If you listen, pay attention and put a little effort in you'll do amazing. Thank you for helping me get back into the medical field, I've always been fascinated by it all. I would definitely recommend my friends and family to CIMS. Thank you Sherrie, Mr. J and Ms. B I can assure you I'll make you proud!
Read More
Jazmine H.
Jun 1, 2023
Awesome program ! Did the MA program, this program helps their students thrive in the field. Even when I was struggling, they helped me a lot to not get behind. The people I've met in my class are just amazing ! I love how they show us real animal organs, so we get an idea on how the heart and kidney works. The teacher Mrs. B , I love how she wants all her students to succeed, and if she sees you struggling at a skill . She does one on one to help you strength your skills! This school really aims for all their students for success! I do recommend for anyone that wants to be a medical Assistant!
Read More